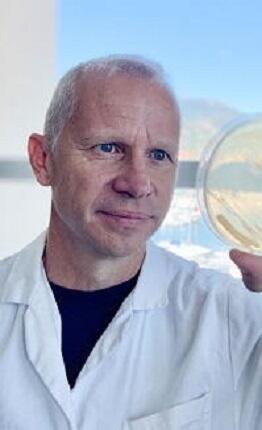
Jean-François Ghiglione

L'annuaire des expertises
Pour toute demande concernant les relations presse Veuillez envoyer un courriel à presse@sorbonne-universite.fr.

Olivier Chaline
Spécialiste d'histoire et d'archéologie maritimes

Isabelle Davion
Histoire contemporaine des pays germaniques et de l’Europe centre-orientale
Contacter par courriel
Jean-François Ghiglione
Écotoxicologie microbienne et pollutions plastiques


